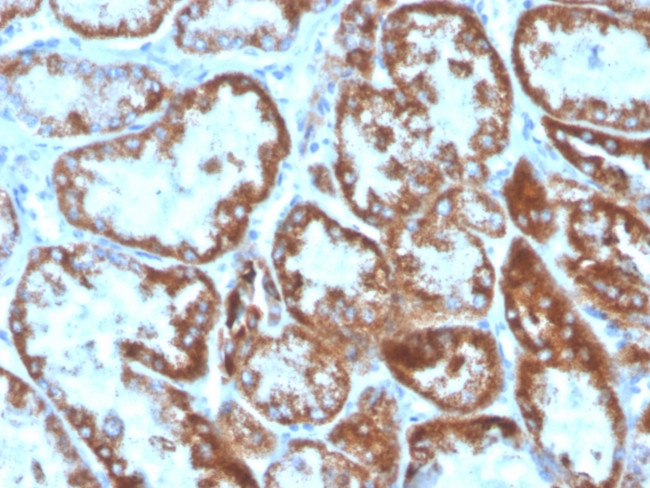
CD137L/4-1BBL/TNFSF9 Antibody in Immunohistochemistry (Paraffin) (IHC (P))
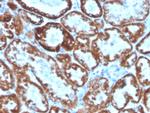
CD137L/4-1BBL/TNFSF9 Antibody in Immunohistochemistry (Paraffin) (IHC (P))

Search
NeoBiotechnologies
CD137L/4-1BBL/TNFSF9 Monoclonal Antibody (CD137L/1547), Biotin
{{$productOrderCtrl.translations['antibody.pdp.commerceCard.promotion.promotions']}}
{{$productOrderCtrl.translations['antibody.pdp.commerceCard.promotion.viewpromo']}}
{{$productOrderCtrl.translations['antibody.pdp.commerceCard.promotion.promocode']}}: {{promo.promoCode}} {{promo.promoTitle}} {{promo.promoDescription}}. {{$productOrderCtrl.translations['antibody.pdp.commerceCard.promotion.learnmore']}}
产品信息
8744-MSM1-B1
种属反应
宿主/亚型
分类
类型
克隆号
抗原
偶联物
形式
浓度
规格
纯化类型
保存液
内含物
保存条件
运输条件
靶标信息
CD137 ligand (CD137L) is a type II membrane protein and part of the TNF superfamily. CD137L is a co-stimulatory molecule that is expressed on antigen presenting cells (DCs, monocytes/macrophages, B cells) and is upregulated upon activation. Its receptor, CD137/4-1BB, is found on a variety of cells, including inflamed endothelial cells, where its expression enhances extravasation of CD137L expressing monocytes. Activated T cells also express CD137, and engagement with CD137L enhances T cell proliferation, IL-2 secretion, survival, and cytotoxic activity. CD137L is also expressed on a majority of B-cell lymphomas, including mantle cell lymphoma, follicular lymphoma, and diffuse large B-cell lymphoma (but it is lacking on Hodgkin lymphoma and T-cell lymphoma). CD137L is also expressed in carcinoma cell lines, and is thought to be involved in T cell-tumor cell interactions.
仅用于科研。不用于诊断过程。未经明确授权不得转售。
篇参考文献 (0)
生物信息学
蛋白别名: 4 1 BB Ligand; 4 1 BBL; 4-1BB ligand; 4-1BBL; 41BB Ligand; 41BBL; CD 137 Ligand; CD 137L; CD137 Ligand; CDw137L; homolog of mouse 4-1BB-L; receptor 4-1BB ligand; TNFRSF9; tumor necrosis factor (ligand) superfamily, member 9; tumor necrosis factor ligand 5A; Tumor necrosis factor ligand superfamily member 9; tumor necrosis factor superfamily member 9; unnamed protein product
基因别名: 4-1BB-L; CD137L; TNFSF9; TNLG5A
UniProt ID: (Human) P41273
Entrez Gene ID: (Human) 8744